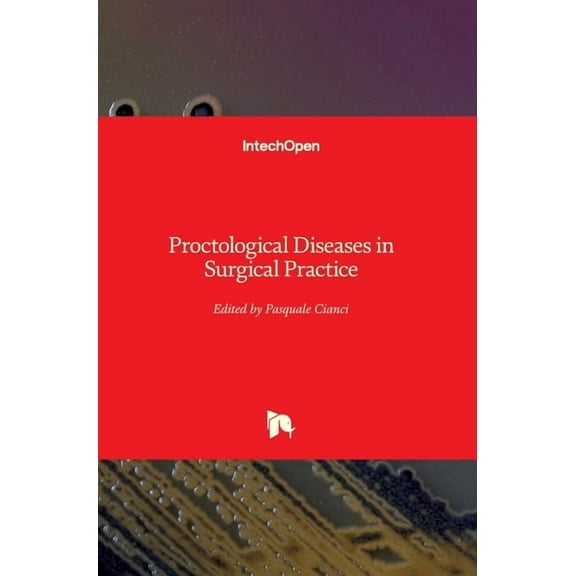
Proctological Diseases in Surgical Practice (Hardcover)

Hero image 0 of 50 Landmark Papers 50 Landmark Papers every Pediatric Surgeon Should Know, (Hardcover), 0 of 1
50 Landmark Papers 50 Landmark Papers every Pediatric Surgeon Should Know, (Hardcover)
(No ratings yet)
Current price is USD$130.00
Price when purchased online
- Free shipping
- Free 90-day returns
How do you want your item?
Try 30 days of Free Shipping with Walmart+! Choose plan at checkout.
Columbus, 43215
Arrives by Sat, Apr 4
Sold and shipped by Walmart.com
Free 90-day returns
This item is gift eligible
Other sellers
$150.76
+ $6.98 shippingShipping, arrives by Thu, Apr 9 to Columbus, 43215
Sold and shipped by Best Prices & Service
Free 30-day returns
Get free delivery, shipping and more*
*Restrictions apply
About this item
Customer ratings & reviews
0 ratings|0 reviews
This item does not have any reviews yet
Related pages
- Paper Pieces English Paper Piecing
- Ellie Claire Gift & Paper Corporation
- Pelosus Paper
- Paper Folding Design
- Papel Seda
- Designing Letterhead
- Reference Crafts & Hobbies Books
- Ribbon Work Crafts & Hobbies Books
- General Crafts & Hobbies Books
- Paper Ephemera Antiques & Collectibles Books
- Origami Crafts & Hobbies Books
- Framing Crafts & Hobbies Books